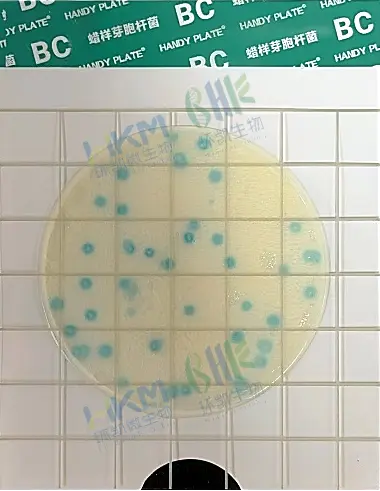
蜡样芽孢杆菌显色测试片

环凯HP015蜡样芽孢杆菌显色测试片 食品致病菌快检合规方案
发布时间:2026-01-30 浏览次数:106
核心提示:蜡样芽孢杆菌作为食源性致病菌,常潜伏于乳制品、糕点、熟肉制品等食品及生产环境中,其耐热毒素易引发肠胃不适,对食品安全构成重大威胁。环凯HP015蜡样芽孢杆菌显色测试片,凭借特异性显色技术实现快速检测,破解传统检测痛点,为食品企业筑牢安全防线。
蜡样芽胞杆菌是引发“炒饭综合征”等食源性疾病的重要病原,且其易污染的食品种类繁多,包括米制品、乳制品、熟肉制品等多种主要食品类别,因此国标要求对相关食品进行蜡样芽胞杆菌检验具有重大的公共卫生意义和市场监管价值。传统采用甘露醇卵黄多粘菌素(MYP)琼脂检测,不仅需24~ 48 小时小时培养周期,操作繁琐且易与近缘菌种混淆,难以满足企业实时巡检、快速排查风险的需求。环凯深耕微生物检测技术,针对性研发显色测试片,以“快、准、简”核心优势,重塑蜡样芽孢杆菌检测流程。
核心技术:特异性显色,一眼锁定目标菌
环凯HP015蜡样芽孢杆菌显色测试片,核心依托微生物代谢酶与特异性显色底物的专属反应机制,实现目标菌的精准识别,无需复杂后续处理,操作门槛大幅降低。
检测时,仅需按标准处理样品并接种于测试片,经30℃±1℃培养18小时后,即可快速判读结果:蜡样芽孢杆菌代谢产生的专属酶会水解底物释放显色基团,使菌落呈现清晰蓝绿色,边缘规整易识别;而枯草芽孢杆菌等近缘菌种无此类反应,菌落不显色,有效规避假阳性干扰,检测特异性远超传统培养基。
产品优势:快准简兼备,适配多场景检测
相较于传统检测方法,环凯蜡样芽孢杆菌显色测试片在效率、精准度、易用性上全面升级,完美适配食品企业日常巡检、原料筛查、成品抽检等多场景需求。
1. 高效提速:24小时出结果,抢占风险管控先机
将传统检测的24~ 48小时周期缩短至18小时,大幅提升检测效率。无论是生产过程中的实时风险排查,还是成品出厂前的快速抽检,都能快速出具结果,为问题产品召回、生产工艺及时调整争取宝贵时间,降低企业运营损失。
2. 精准抗干扰:高特异性,降低误判成本
专属显色体系精准靶向蜡样芽孢杆菌,有效排除近缘菌种及其他杂菌干扰,假阳性率显著低于传统MYP琼脂。清晰的菌落显色效果,无需专业人员复杂判读,也能精准区分目标菌,减少因误判导致的资源浪费与安全隐患。
3. 操作便捷:简化流程,适配各类实验室
测试片采用预制培养基设计,无需人工配制、灭菌、倒平板等复杂步骤,仅需完成样品处理与接种,大大降低操作难度与污染风险。无论是大型食品企业的专业实验室,还是中小型企业的基层检测岗,都能快速上手,实现标准化检测操作。

4. 场景适配广:覆盖全品类食品检测需求
可广泛应用于乳制品、糕点、面包、熟肉制品、方便食品、饮料等易受蜡样芽孢杆菌污染的食品品类,同时适配生产车间设备表面、操作台、环境拭子等场景的微生物检测,一站式满足企业全流程风险管控需求。
实用指南:测试片正确使用,保障检测精准度
为确保检测结果准确可靠,使用环凯蜡样芽孢杆菌显色测试片时需注意三点:一是样品处理需严格遵循国家标准,确保样品均匀性与代表性;二是接种后需及时置于30℃±1℃恒温培养箱中培养,避免温度波动影响菌落生长与显色效果;三是判读时需在自然光或白光下观察,避免强光直射导致显色判断误差。
环凯 HP015 蜡样芽孢杆菌显色测试片产品详情速览:
- 检测对象:蜡样芽孢杆菌(Bacillus cereus)
- 检测原理:特异性代谢酶 + 显色底物反应
- 检测时间:18–24 h
- 培养条件:30 ±1 ℃
- 结果特征:蓝绿色菌落,边缘清晰
- 对比方法:MYP 琼脂
- 适用标准:GB 相关食品微生物检测方法
- 适用场景:食品、环境、设备表面、原料、成品
